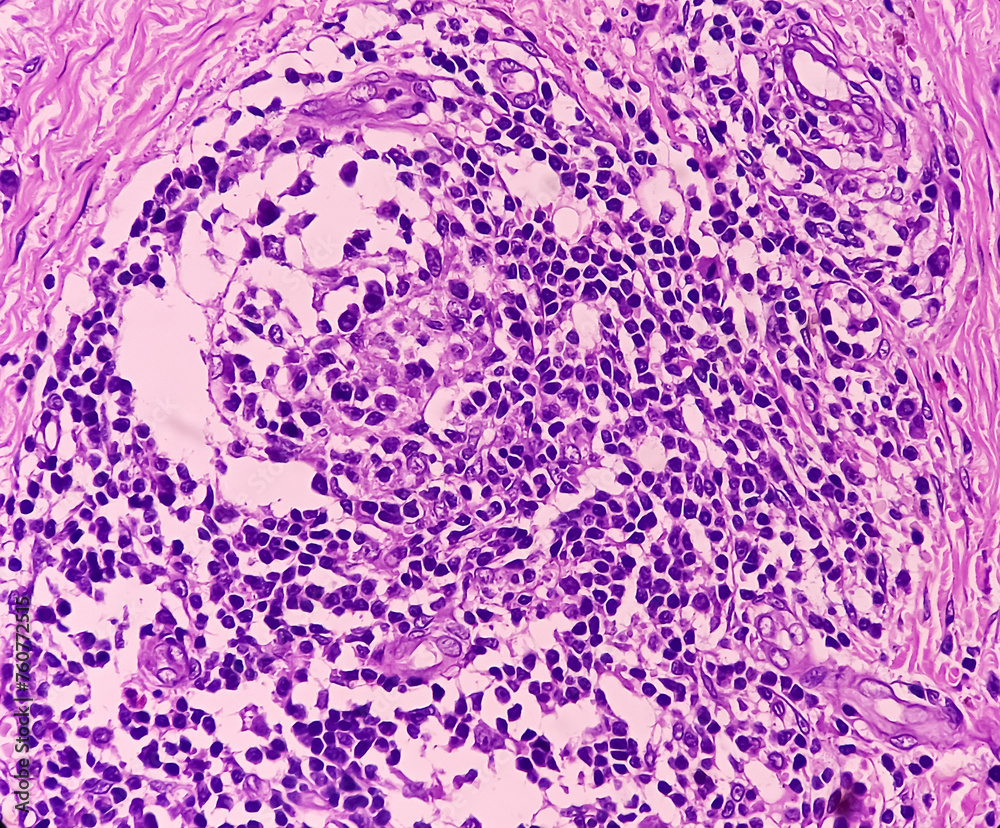

Плоскоклеточный Рак Кожи Картинки
Плоскоклеточный Рак Кожи Картинки 108 фото
Дождь И Солнце Картинки
Очень Красивый Девчонки Фото
Цвет Темный Дуб Фото
Картинки Мама С Ребенком На Кухне
Откровенные Фотографии Одиноких Разведенок Междуреченска
Волгоградская 5 Фото
Карие Глаза Фото Женские На Аву
Екатерина Усик Горячие Фото
С Приятным Днем Картинки Веселые
Отбивная Говядина Рецепт С Фото